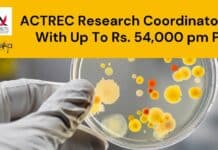
ACTREC Research Coordinator Job With Up To Rs. 54,000 pm Pay ACTREC Research Coordinator Post

ICAR-Indian Institute of Soybean Research JRF Job Recruitment
ICAR-IISR JRF Job Recruitment For MSc Plant Sciences & Life Sciences
ICAR-IISR JRF Job Recruitment For MSc Plant Sciences & Life Sciences. ICAR-Indian Institute of...
Clinical Trial Co-ordinator Job Opening at ACTREC, Attend Walk-In
Clinical Trial Co-ordinator Job Opening at ACTREC, Attend Walk-In
Clinical Trial Co-ordinator Job Opening at ACTREC, Attend Walk-In. MSc Life Sciences can apply for a...
BHU Molecular Biology Unit RA Job Opening, Applications Invited
BHU Vacancy RA 2022 - Biotech, Biochem, Mol Bio & Zoology Apply
BHU Vacancy RA 2022 - Biotech, Biochem, Mol Bio & Zoology Apply. PhD...
IISER TVM CRISPR Project Job For MSc, PhD Biological & Life Sciences
IISER TVM Project Vacancy For Biological & Life Sciences
IISER TVM Project Vacancy For Biological & Life Sciences. IISER TVM is hiring Biological Sciences &...
Bayer Recruiting Agriculture Sciences Candidates For Executive Vacancy
Bayer Agriculture Science Job, Online Application Process
Bayer Agriculture Science Job, Online Application Process. Bayer Karnataka Jobs. MSc Agriculture Science Bayer India Vacancies. Interested and...
Sharda University & University of Delhi South Campus JRF/SRF Recruitment
Sharda University Research Job - University of Delhi South Campus
This job expires in
This job has expired
SHARDA UNIVERSITY
and
UNIVERSITY OF DELHI- SOUTH CAMPUS
Advertisement for the post...
CSIR-CIMAP Project Associate/Assistant Jobs For BSc, BTech, MSc & PhD, Attend Walk-In
CSIR-CIMAP Job Openings 2022 - Attend Walk-In-Interview
CSIR-CIMAP Job Openings 2022 - Attend Walk-In-Interview. MSc Plant Biotech, Plant Breeding & Genetics, Biotech, Biochem, Botany and...
UPSC Jobs 2022 For Biotech, Biochem, Botany, Zoology & Human Genetics – Apply Online
UPSC Jobs 2022 Notification For Biotech, Biochem, Botany, Zoology & Human Genetics
UPSC Jobs 2022 Notification For Biotech, Biochem, Botany, Zoology & Human Genetics. UPSC...
CDFD MSc, BTech & MTech SRF Recruitment – Apply Online
CDFD SRF Job Opening - Online Application Process
CDFD SRF Job Opening - Online Application Process. MSc/ BTech and MTech jobs at the Centre for...
JNCASR-IISc Project Research Associate, R&D Assistant Recruitment 2022
JNCASR Vacancies For PhD Mol Bio, Cell Biology - Applications Invited
JNCASR Vacancies For PhD Mol Bio, Cell Biology - Applications Invited. Research Associate positions...
20+ Sports Authority of India Life Sciences Performance Analysts Jobs With Rs. 60,000 pm...
SAI Life Sciences Jobs For BSc & MSc - Applications Invited
SAI Life Sciences Jobs For BSc & MSc - Applications Invited. BSc Life Sciences...
Biotecnika Times Newsletter 09.09.2022 FSSAI Internship + Stipend, Biocon Certificate Program, Govt BCIL Jobs...
Biotecnika Times - FSSAI Internship + Stipend, Govt BCIL Jobs
FSSAI Internship Scheme For October 2022 With Rs. 10,000 Stipend, Apply Online
FSSAI Internship 2022 June...
Amity University Kolkata Project Assistant Recruitment In DBT-Ramalingaswami Fellowship Project
Amity University Kolkata Project Assistant Recruitment In DBT-Ramalingaswami Fellowship Project
Recruitment of PROJECT ASSISTANT at Amity Institute of Biotechnology, Amity University Kolkata under DBT -...
CBMR RA & JRF Jobs For Biotech, Biochem – Applications Invited
CBMR Research Recruitment 2022 - Applications Invited
CBMR Research Recruitment 2022 - Applications Invited. Centre of Biomedical Research Research Associate & Junior Research Fellow jobs....
ACTREC Research Coordinator Job With Up To Rs. 54,000 pm Pay
ACTREC Research Coordinator Post With Up To Rs. 54,000 pm Pay
ACTREC Research Coordinator Post With Up To Rs. 54,000 pm Pay. MSc Microbiology /...